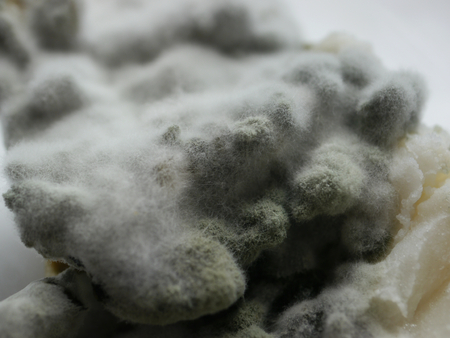
fragment of not fresh mouldy foodの写真素材

写真素材 - fragment of not fresh mouldy food
キーワード
- bad
- bakery
- bread
- cancerogenic
- carcinogenic
- closeup
- contaminated
- dangerous
- decay
- decomposed
- dew
- disagreeable
- drop
- food
- fungal
- fungi
- fungus
- grey
- growing
- harmful
- inedible
- infected
- loathsome
- macro
- micro
- mildew
- mildewed
- moldiness
- mould
- mouldy
- nauseating
- old
- penicillin
- poisonous
- putrid
- repulsive
- rotten
- rubbish
- seeds
- sickening
- spoiled
- spoilt
- tainted
- toxic
- uneatable
- unedible
- unhygienic
- unpleasant
- white
- mold
類似作品
Close-up of Muc...
Backgrounds of ...
Mold close-up m...
Mold close-up m...
Mold close-up m...
blue mold backg...
A piece of food...
fungal mildew o...
Fungi culture o...
mold on pickled...
Close-up on tex...
Green fabric te...
macro of mold r...
blue mold backg...
Pumpkin covered...
cell tissue und...
Yellow fungus ...
Designed grunge...
Shot of mold on...
A close up of a...
Abstract gold s...
the very large ...
mold colonies
Mold. Nice mold...
Rotten, spoiled...
A piece of food...
Yellow fungus ...
Mold close-up m...
Macro texture o...
Concrete marble...
Spores of fungu...
mold on eggplan...
natural mold on...
Mushroom cultiv...
Mold close-up m...
Green mould bac...
macro of mold r...
Grunge wall. Us...
Close up of mol...
The surface of ...
Blurred backgro...
fungal mildew o...
Abstract closeu...
This image appe...
artistic mold b...
Macro detail of...
macro, pumpkin ...
microbiology ba...
Beautiful macro...